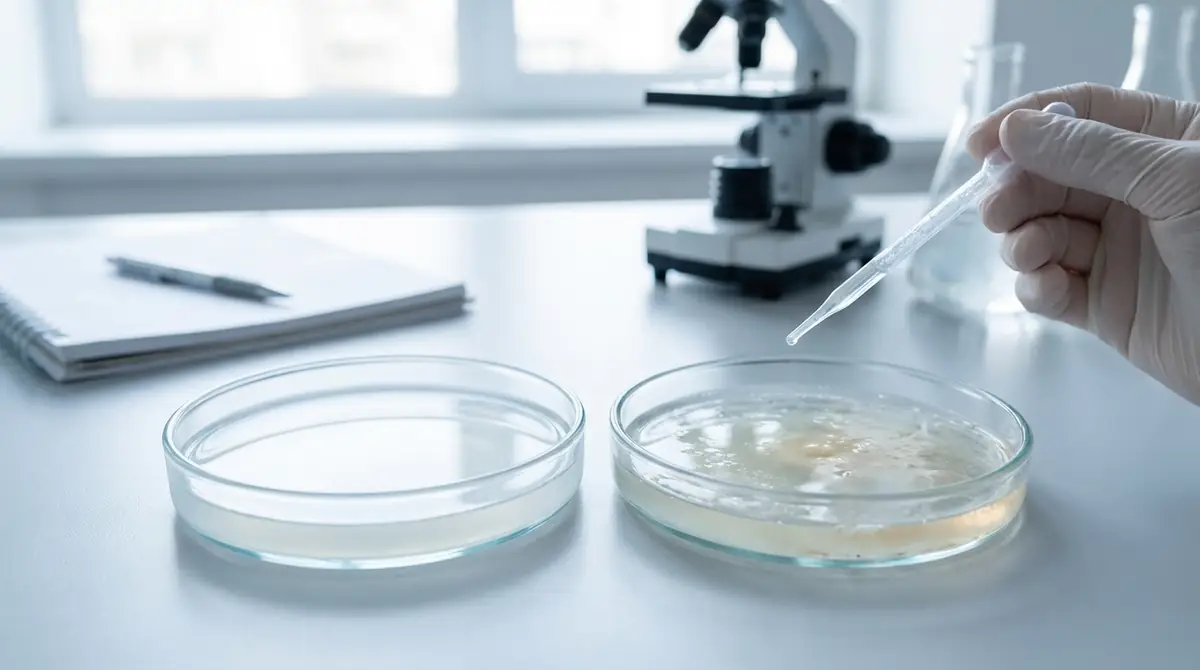
【症状別】正常な白濁と病気を見分けるチェックリスト

レオパードゲッコーの目が突然白くなっていて、「病気なの?」「それとも脱皮?」と不安になっていませんか?目の白濁は脱皮の前兆として起こる正常な生理現象の場合もあれば、感染症や脱皮不全など早急な対処が必要なケースもあります。この記事では、目が白くなる5つの原因とそれぞれの見分け方、自宅でできるケア方法、そして病院に行くべき判断基準まで、飼い主が本当に知りたい情報をわかりやすく解説します。
【結論】レオパの目が白いときの緊急度チェック

レオパードゲッコー(以下レオパ)の目が白くなったとき、まず最初にすべきことは緊急度の判断です。
白濁の原因はさまざまで、放置しても問題ないケースと、数日以内に受診しなければ失明リスクがあるケースが混在しています。
焦って誤ったケアを行うと症状を悪化させる恐れがあるため、まず以下の緊急度チェックで現在の状況を把握してください。
今すぐ病院へ行くべき症状
以下の症状が1つでも当てはまる場合は、24〜48時間以内に爬虫類対応の動物病院を受診することを強くおすすめします。
- 目やに(黄色・緑色・膿状)が出ている
- 目の周囲が腫れている、または赤みがある
- 片目だけが白濁しており、脱皮の兆候(体全体のくすみ)がない
- 目を細めている・しきりにこすっている
- 白濁が2週間以上続いている
- 食欲が著しく低下している
- 目の表面に膜や異物が付着しているように見える
特に目やにや腫れを伴う白濁は細菌・真菌感染の可能性が高く、抗生物質や抗真菌薬による治療が必要です。
自己判断で市販薬を使うと菌の耐性化を招く恐れがあるため、必ず獣医師の診察を受けてください。
様子見でOKなケース
次の条件がすべて当てはまる場合は、脱皮に伴う正常な白濁である可能性が高く、数日間の様子見が可能です。
- 両目が同時に白濁している
- 体全体の皮膚もくすんでいる(全身の脱皮前兆がある)
- 目やに・腫れ・赤みが一切ない
- 食欲はやや低下しているが完全に止まっていない
- 普段と変わらず活動している
- 白濁が出てから1〜2週間以内
このような場合は脱皮が完了するまで湿度を60〜80%に保ち、ウェットシェルターを設置してサポートしましょう。
ただし、脱皮完了後も白濁が解消されない場合は脱皮不全(アイキャップ残り)の疑いがあるため、速やかに対処が必要です。
レオパの目が白くなる5つの原因と見分け方

レオパの目が白くなる原因は大きく5つに分類されます。
それぞれの特徴を理解することで、自宅でも原因をある程度特定できるようになります。
原因①脱皮の前兆(最も多いケース)
レオパの目が白くなる原因として最も多いのが脱皮の前兆です。
レオパは脱皮の3〜7日前になると、古い皮膚と新しい皮膚の間にリンパ液が溜まり始め、目を覆う透明な鱗(アイキャップ)も白濁して見えるようになります。
この状態は病気ではなく、正常な生理現象です。
見分け方のポイント:体全体の皮膚が白っぽくくすんでいるか確認してください。
目だけでなく体全体がくすんでいれば、脱皮前兆の可能性が非常に高いです。
また、脱皮前は光を嫌がる傾向があるため、シェルターに引きこもる時間が増えることも特徴のひとつです。
脱皮が始まるとほとんどの場合、目の白濁も自然に解消されます。
原因②脱皮不全によるアイキャップの残り
アイキャップ(目を覆う透明鱗)が脱皮の際にうまく剥がれず残ってしまう状態を「アイキャップ残り」と呼びます。
これは脱皮不全の一種で、湿度が低い環境や栄養状態の悪化、体調不良のときに起こりやすいトラブルです。
見分け方のポイント:脱皮が完了した後(体の皮は剥けている)にもかかわらず、目だけが白濁したままの状態が続いている場合はアイキャップ残りを疑います。
よく観察すると、目の表面に薄い膜が貼り付いているように見えることがあります。
放置すると目への圧迫や感染症の原因になるため、適切なケアが必要です。
具体的な対処法は後述の「温浴ケアの手順」で詳しく説明します。
原因③細菌・真菌による感染症
細菌や真菌(カビ)の感染によって目が白濁するケースは、放置すると失明につながる可能性がある深刻な状態です。
不衛生な飼育環境・傷口からの感染・免疫力の低下などが主な原因として挙げられます。
見分け方のポイント:感染症の場合は白濁に加えて、以下のような症状を伴うことが多いです。
- 目やに(特に黄色・緑色・膿のような色)が出る
- 目の周囲が腫れている
- 目が半開きのまま閉じられない
- 患部から異臭がする
これらの症状がある場合は自己判断でのケアは危険です。
獣医師による検査(細菌培養検査など)で原因菌を特定し、適切な抗生物質や抗真菌薬で治療する必要があります。
原因④外傷や異物混入
床材の粒子や砂、ケージ内のデコレーションへの衝突など、物理的な刺激によって目が傷つき白濁することもあります。
見分け方のポイント:外傷の場合は多くの場合、脱皮とは無関係のタイミングで突然片目が白濁します。
目を頻繁にこすったり、床に顔を擦り付けるような行動が見られることもあります。
また、砂系の床材(カルシウムサンド・砂漠砂など)を使用している環境では、目への砂の入り込みによる白濁リスクが高まります。
異物混入が疑われる場合は、まず温浴で洗い流すことを試みますが、改善しなければ速やかに受診してください。
原因⑤先天性異常・加齢による白内障
まれなケースですが、先天性の眼異常や加齢による白内障で目が白濁することもあります。
白内障は水晶体のタンパク質が変性して白く濁る疾患で、人間と同様にレオパでも高齢になるほど発症リスクが高まります。
レオパの平均寿命は10〜15年とされており、7〜8年以上生きた個体では加齢による眼疾患を考慮する必要があります。
見分け方のポイント:白内障の白濁は急激に起こるのではなく、数週間〜数ヶ月かけてゆっくりと進行するのが特徴です。
脱皮との関係なく常に白濁しており、視力の低下(餌への反応が悪くなる・壁に衝突するなど)を伴う場合は白内障の可能性があります。
現状、爬虫類の白内障に対する有効な治療法は限られており、獣医師と相談しながらQOL(生活の質)を維持するケアが中心となります。
【症状別】正常な白濁と病気を見分けるチェックリスト
ここでは症状のパターン別に、正常な白濁と病気を区別するための具体的なチェックリストをご紹介します。
自宅での観察に活用してください。
両目が白い場合のチェックポイント
両目が同時に白濁している場合は、脱皮前兆の可能性が高いです。
以下の項目を確認して判断しましょう。
| チェック項目 | 正常(脱皮前) | 要注意 |
|---|---|---|
| 体全体のくすみ | あり | なし(目だけ白い) |
| 目やにの有無 | なし | あり |
| 目の周囲の腫れ | なし | あり |
| 食欲 | やや低下 | 完全停止 |
| 活動量 | ほぼ通常 | 著しく低下 |
| 白濁の持続期間 | 1〜2週間以内 | 2週間以上 |
「要注意」の項目に1つでも当てはまる場合は、脱皮以外の原因を疑い、早めに獣医師に相談することをおすすめします。
片目だけ白い場合のチェックポイント
片目だけが白濁している場合は、脱皮前兆の可能性はほぼゼロです。
脱皮は全身で同時に進行するため、片目だけ白濁するという現象は通常起こりません。
片目だけの白濁が見られる場合は、以下の原因を疑ってください。
- 脱皮不全(アイキャップ残り):体の脱皮は完了しているが片目のアイキャップだけ剥がれ残っている
- 外傷・異物混入:その目だけ傷ついた・砂が入った
- 片側性の感染症:片目に細菌や真菌が感染した
片目の白濁は原則として1〜2日以内に原因を特定し、適切な対処を行う必要があります。
原因が不明な場合や症状が改善しない場合は迷わず受診してください。
目やに・腫れを伴う場合は要注意
目やにや腫れを伴う白濁は、感染症または重篤な外傷のサインとして捉えてください。
目やにの色・質感によって原因をある程度推測できます。
- 透明〜白色の目やに:ウイルス性感染や軽度の炎症の可能性
- 黄色〜緑色の目やに:細菌性感染(膿が出ている状態)の可能性が高い
- 黒っぽい目やに:壊死組織や真菌感染の可能性
腫れがある場合は炎症が進行している証拠であり、放置すると眼球への圧力が高まって視力に永続的なダメージを与える可能性があります。
目やに・腫れがある場合は自宅ケアを試みず、即日または翌日に受診してください。
レオパの目が白いときの対処法【原因別の手順】

原因が特定できたら、それぞれに適した対処法を実践しましょう。
間違ったケアは症状を悪化させるリスクがあるため、原因に合わせた正しい手順を守ることが重要です。
脱皮前兆の場合:湿度管理で脱皮をサポート
脱皮前兆による白濁には、ケージ内の湿度を60〜80%に高めることが最も効果的な対処法です。
湿度が十分であれば、大多数のレオパは自力で脱皮を完了させます。
湿度を上げる具体的な方法:
- ウェットシェルターを設置する:シェルターの上部に水を張るタイプのものが最も効果的。水は毎日交換してカビを防ぐ。
- 水容器のサイズを大きくする:蒸発量が増えて自然に湿度が上がる。
- 霧吹きでケージ内を湿らせる:ケージの壁面に1日1〜2回スプレー。レオパに直接かけないよう注意。
- 湿度計で数値を確認する:アナログ・デジタル問わず必ず設置し、60%以上を維持できているか確認する。
脱皮は通常1〜3日で完了します。
脱皮完了後に白濁が解消されていれば問題ありません。
脱皮中はなるべくハンドリングを避け、ストレスを与えないことも重要なポイントです。
脱皮不全(アイキャップ残り)の場合:温浴ケアの手順
アイキャップが残っている場合は、温浴によって皮膚を柔らかくしてから自然に剥がれるのを待つ方法が基本的な対処法です。
決して無理に剥がそうとしてはいけません。
温浴ケアの手順:
- 30〜32℃のぬるま湯をタッパーや小型容器に2〜3cm程度張る(レオパが溺れない深さ)。
- レオパを容器に入れ、5〜10分間温浴させる。
- 温浴後、湿らせた綿棒で目の周囲を優しくなでる。力を入れず、皮が浮いてきたら自然に剥がれるのを待つ。
- 1回で取れない場合は翌日また温浴を繰り返す。
- 2〜3回の温浴でも改善しない場合は動物病院を受診する。
温浴中は目を離さず、レオパが暴れた場合は無理に続けず一度中断してください。
温浴後は清潔なティッシュやタオルで水分をやさしく拭き取り、体温が下がらないよう素早くケージに戻しましょう。
絶対にやってはいけないNG行動3選
目のトラブルに焦った飼い主が陥りやすいNG行動を3つ紹介します。
これらの行動は症状を大幅に悪化させる可能性があるため、絶対に行わないでください。
NG行動①:アイキャップを無理やり剥がす
ピンセットや爪で残ったアイキャップを強引に引き剥がすと、眼球表面を傷つけ、最悪の場合失明につながります。
必ず温浴で皮を柔らかくしてから、自然に剥がれる状態を待ちましょう。
NG行動②:市販の人間用・犬猫用目薬を使う
人間用や犬猫用の目薬に含まれる成分は、レオパの眼粘膜に適していない場合があります。
特にステロイド系の目薬は免疫を抑制し、感染症を悪化させるリスクがあります。
爬虫類に使用できる点眼薬は必ず獣医師の処方を受けてください。
NG行動③:症状が出てから2週間以上放置する
脱皮前兆以外の原因による白濁を「そのうち治るだろう」と放置し続けると、感染症が全身に広がったり、眼球が取り返しのつかないダメージを受けたりする場合があります。
目の異常は最長でも2週間を目処に改善が見られない場合は必ず受診するというルールを守ってください。
病院に行くべき判断基準と受診の流れ

ここでは、病院に行くべきかどうかの判断基準と、実際に受診する際に知っておくべき情報をまとめます。
爬虫類対応の動物病院の探し方
レオパの目のトラブルを診てもらうためには、爬虫類の診察に対応している動物病院を選ぶことが重要です。
一般的な犬猫専門の動物病院では爬虫類の診察に対応していない場合が多いため、事前に確認が必要です。
病院の探し方:
- 「レオパ 動物病院 ○○市」「爬虫類 エキゾチック 動物病院 ○○」などで検索する
- レオパのコミュニティやSNSで近隣の飼い主から口コミを集める
- 爬虫類専門のペットショップに問い合わせて紹介してもらう
- 受診前に電話で「ヒョウモントカゲモドキの目の治療が可能か」を確認する
緊急時に備えて、近隣の爬虫類対応病院を日頃から把握しておくことが大切です。
特に夜間や休日に症状が悪化した場合に備え、夜間対応可能な病院も事前にリストアップしておくと安心です。
受診時に準備すべきもの・伝えるべき情報
スムーズな診察のために、以下を事前に準備しておきましょう。
持参すべきもの:
- レオパを入れた通気性のあるプラケース(移動中の保温に注意)
- 最近の食事記録(最後に食べた日時・量)
- 目の白濁が始まった日・経過を記録したメモ
- 症状が分かる写真・動画(事前に撮影しておくと便利)
獣医師に伝えるべき情報:
- 個体の年齢・性別・入手経路・飼育年数
- ケージのサイズ・温度・湿度設定
- 使用している床材の種類
- 症状が出始めた時期と経過(両目か片目か、目やにの有無など)
- 直近の脱皮の状況(いつ脱皮したか)
- これまでにかかった病気・受けた治療歴
情報が詳細であるほど、獣医師は迅速かつ正確に診断を下せます。
目の病気の治療内容と費用の目安

動物病院でどのような治療が行われるのか、また費用がどの程度かかるのかを事前に把握しておくと、受診への心理的ハードルが下がります。
一般的な診察・治療の流れ
レオパの目のトラブルで受診した場合、一般的に以下の流れで診察・治療が進みます。
- 問診・視診:飼育環境・症状の経過を確認し、外観から目の状態を観察する。
- 眼科的検査:必要に応じて検眼鏡や細隙灯を使用して眼球内部を確認する。
- 細菌培養検査:感染症が疑われる場合は、目やにや患部から検体を採取して原因菌を特定する(結果が出るまで約1週間程度かかることが多い)。
- 治療:原因に応じて抗生物質点眼薬の処方・アイキャップの処置・全身投薬などを実施する。
- 経過観察・再診:1〜2週間後に再診して回復状況を確認する。
感染症の場合は投薬期間が2〜4週間程度になることが多く、飼い主が自宅で点眼薬を投与するケースもあります。
治療費の相場(症状別の目安)
爬虫類の診療費は動物病院によって異なりますが、以下が一般的な目安です。
なお、爬虫類には公的な健康保険制度はなく、費用は全額自己負担となります。
| 症状・処置 | 費用の目安 |
|---|---|
| 初診料 | 2,000〜5,000円 |
| 視診・問診のみ | 3,000〜6,000円(初診料含む) |
| アイキャップ除去処置 | 3,000〜8,000円 |
| 細菌培養検査 | 5,000〜10,000円 |
| 抗生物質点眼薬(処方) | 2,000〜5,000円 |
| 全身への抗生物質投薬(注射) | 3,000〜8,000円/回 |
| 感染症の総治療費(目安) | 15,000〜40,000円程度 |
複数回の通院が必要な場合や、検査項目が多い場合はさらに費用がかかることがあります。
爬虫類向けのペット保険に加入しておくことで、費用の一部をカバーできる場合があります。
飼育を始める前に保険の検討もおすすめします。
レオパの目のトラブルを予防する飼育環境

目のトラブルの多くは適切な飼育環境を整えることで予防できます。
日頃のケアで愛するレオパを守りましょう。
湿度管理が最重要|適正湿度と維持方法
脱皮不全やアイキャップ残りの最大の予防策は適切な湿度管理です。
レオパの飼育に適した湿度は通常時40〜60%、脱皮前後は60〜80%が理想的です。
湿度を適切に維持するためのポイント:
- ウェットシェルターを常設:内部の湿度が80%以上に保たれるため、脱皮前に特に有効。水は毎日新鮮なものに交換する。
- 湿度計を必ず設置:デジタル式が精度が高くおすすめ。最低でも1日1回数値を確認する。
- 冬場の乾燥対策:暖房使用時は湿度が大幅に下がるため、加湿器の使用や霧吹きの頻度を増やす。
- 床材の保湿力を活用:ヤシガラ土やテラリウムソイルは水分を保持しやすく、湿度維持に効果的。
一方で、湿度が高すぎる(90%以上が常時続く)と細菌・真菌の繁殖リスクが高まるため、換気も適切に行ってください。
目に優しい床材の選び方
床材の種類によっては目への異物混入リスクが高まります。
目のトラブル予防の観点から、以下の基準で床材を選びましょう。
| 床材の種類 | 目へのリスク | 評価 |
|---|---|---|
| 爬虫類用ペーパータオル・キッチンペーパー | ほぼなし | ◎ 最も安全 |
| テラリウムソイル(爬虫類用土) | 低い | ○ おすすめ |
| ヤシガラ土(粉砕タイプ) | 低〜中程度 | △ 粒が細かいものは注意 |
| カルシウムサンド・砂漠砂 | 高い | ✕ 目への混入リスク大 |
| ウォールナットサンド | 高い | ✕ 目・消化器への誤飲注意 |
初心者にはキッチンペーパーかペーパータオルが最も扱いやすく安全です。
ナチュラルな見た目を重視する方にはテラリウムソイルが適しています。
週1回の健康チェック習慣で早期発見
目のトラブルを早期発見するために、週1回の定期的な健康チェックを習慣にしましょう。
チェックリスト(週1回):
- 目の白濁・目やに・腫れがないか
- 体重の変化(デジタルキッチンスケールで計測)
- 皮膚の状態(脱皮片の残りがないか)
- 排泄物の状態(下痢・未消化・無排泄がないか)
- 食欲・活動量の変化
記録をノートやスマートフォンのメモアプリに残しておくと、異変があったときに獣医師へ正確な情報を伝えられます。
体重は毎週計測して増減を記録しておくことで、食欲低下のサインを数値で把握できます。
レオパの目が白いときによくある質問

Q.脱皮前の白濁と病気の白濁は素人でも見分けられる?
A: 多くの場合、ある程度の見分けは可能です。
脱皮前兆の白濁は「両目同時・体全体のくすみあり・目やに・腫れなし」という特徴があります。
一方、病気の白濁は「片目のみ・体のくすみなし・目やにや腫れを伴う」ことが多いです。
ただし、アイキャップ残りは脱皮完了後に残るため、体が正常に見えても目だけ白いケースで気付きにくいことがあります。
判断に迷う場合は、獣医師に写真を送って相談するのが最も確実です。
Q.アルビノ系のレオパは目のトラブルが多い?
A: アルビノ系(トレンパーアルビノ・ベルアルビノ・レインウォーターアルビノなど)のレオパは、色素欠乏によって目が光に非常に敏感という特徴があります。
強い光への長時間露出はストレスや目の炎症につながる可能性があるため、照明の強さや点灯時間に配慮が必要です。
ただし、目のトラブル(感染症・脱皮不全など)の発生率自体がアルビノだから特別に高いというわけではなく、適切な飼育環境を整えることが最重要です。
Q.市販の目薬を使っても大丈夫?
A: 市販の目薬(人間用・犬猫用)の使用は推奨しません。
人間用目薬に含まれる防腐剤(ベンザルコニウム塩化物など)はレオパの繊細な眼粘膜を刺激する可能性があります。
ステロイド成分を含む目薬は感染症を悪化させるリスクがあります。
唯一の例外として、防腐剤無添加の生理食塩水(0.9%塩化ナトリウム水溶液)で目を優しく洗い流すことは、異物混入が疑われる場合に限り応急処置として許容されます。
それ以外の点眼薬は必ず獣医師の処方を受けてください。
Q.目が白いまま何日様子を見ていい?
A: 脱皮前兆が明らかな場合は最長14日間(2週間)を目安に様子を見ることができます。
通常、脱皮は1〜3日で完了するため(前兆の白濁開始から数えると最大1〜2週間)、それ以上白濁が続く場合はアイキャップ残りや別の原因を疑ってください。
片目だけの白濁・目やに・腫れを伴う場合は様子見をせず、1〜2日以内に受診することを強くおすすめします。
「とりあえず1週間様子を見ます」という判断が症状の重篤化につながるケースが多いため、迷ったら早めに受診するのが最善策です。
まとめ:レオパの目の白濁は原因特定が最優先

レオパの目が白くなる原因は多岐にわたりますが、適切な対処をするためにはまず原因を正確に特定することが最優先です。
この記事のポイントをまとめます。
- 両目が白く体全体がくすんでいれば脱皮前兆:湿度60〜80%を維持して自然な脱皮をサポートする。
- 脱皮完了後も目だけ白いならアイキャップ残り:30〜32℃の温浴と湿らせた綿棒で優しくケアする。2〜3回改善しなければ受診。
- 目やに・腫れ・片目の白濁は感染症や外傷のサイン:自宅ケアは試みず1〜2日以内に爬虫類対応の動物病院を受診する。
- 市販の目薬・強引なアイキャップ除去は絶対NG:誤った処置が症状を悪化させる。
- 予防には湿度管理と週1回の健康チェックが効果的:日頃のケアでほとんどのトラブルは未然に防げる。
愛するレオパの目の異変に気付いたとき、この記事が冷静な判断の助けになれば幸いです。
迷ったときは早めに爬虫類専門の獣医師に相談することが、レオパの健康を守る最善の行動です。










コメント